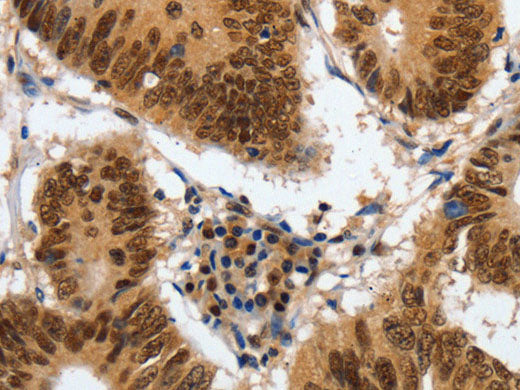
COPS5 Polyclonal Antibody Store at -20°C

COPS5 Polyclonal Antibody Store at -20°C
Couldn't load pickup availability

Still have questions? Ask our experts!
COPS5 Polyclonal Antibody Store at -20°C
| SKU # | E-AB-10415 |
| Reactivity | Human, Mouse |
| Host | Rabbit |
| Applications | WB, IHC |
Product Details
| Isotype | IgG |
| Host | Rabbit |
| Reactivity | Human, Mouse |
| Applications | WB, IHC |
| Clonality | Polyclonal |
| Immunogen | Recombinant protein of human COPS5 |
| Abbre | COPS5 |
| Synonyms | 38 kDa Mov34 homolog, COP9 (constitutive photomorphogenic) homolog subunit 5, COP9 constitutive photomorphogenic homolog subunit 5, COP9 signalosome complex subunit 5, COP9 signalosome subunit 5, COPS 5, CSN 5, CSN5, Cop9 subunit 5, JAB 1, Jun activation, cops5 |
| Swissprot | |
| Calculated MW | 38 kDa |
| Cellular Localization | Cytoplasm. Nucleus. |
| Concentration | 0.9 mg/mL |
| Buffer | Phosphate buffered solution, pH 7.4, containing 0.05% stabilizer and 50% glycerol. |
| Purification Method | Affinity purification |
| Research Areas | Cancer, Cell Biology, Epigenetics and Nuclear Signaling, Neuroscience, Signal Transduction |
| Conjugation | Unconjugated |
| Storage | Store at -20°C Valid for 12 months. Avoid freeze / thaw cycles. |
| Shipping | The product is shipped with ice pack,upon receipt,store it immediately at the temperature recommended. |
Related Reagents
| Applications | Recommended Dilution |
| WB | 1:1000-1:5000 |
| IHC | 1:150-1:500 |
Background
The protein encoded by this gene is one of the eight subunits of COP9 signalosome, a highly conserved protein complex that functions as an important regulator in multiple signaling pathways. The structure and function of COP9 signalosome is similar to that of the 19S regulatory particle of 26S proteasome. COP9 signalosome has been shown to interact with SCF-type E3 ubiquitin ligases and act as a positive regulator of E3 ubiquitin ligases. This protein is reported to be involved in the degradation of cyclin-dependent kinase inhibitor CDKN1B/p27Kip1. It is also known to be an coactivator that increases the specificity of JUN/AP1 transcription factors.